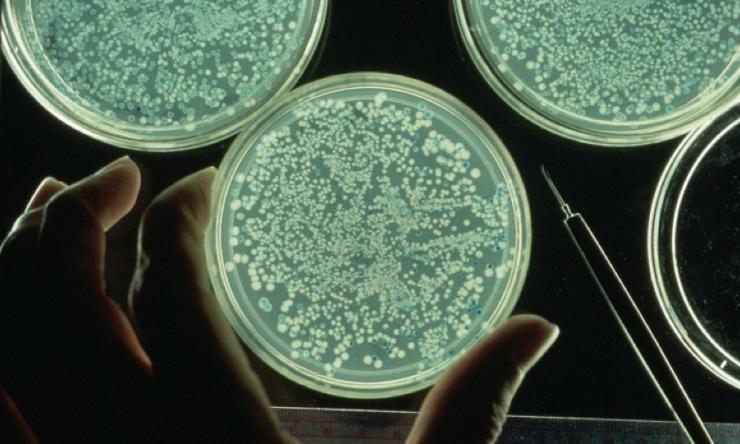
Human Microbiome Research

$11.8 million contract funds microbiome work in type 1 diabetes
An $11.8 million, three-year contract with the www.nih.gov and the University of South Florida in Tampa will enable the Alkek Center for Metagenomics and Microbiome Research at Baylor College of Medicine in Houston to help determine if and how the communities of bacteria, viruses, fungi and other single-celled organisms that inhabit the body (the microbiome) affect the risk of, or are associated with, development of type 1 diabetes—a disease that usually starts in childhood or young adulthood.
"The goal of this research is to look for microbial association and a potential viral trigger for the initiation of this disease in people who are genetically susceptible to it," said Dr. Joseph Petrosino, director of the CMMR and an assistant professor of molecular virology & microbiology, molecular and cellular biology at BCM. Dr. Richard E. Lloyd, professor of molecular virology & microbiology at BCM is a co-principal investigator on the project, and Dr. Rob Knight, associate professor of molecular biophysics at University of Colorado in Boulder, is a lead co-investigator.
Others working with Petrosino at Baylor include Dr. Aleksandar Milosavljevic, associate professor of molecular and human genetics, who will provide analysis of the data, and Dr. Richard Gibbs, director of the Baylor Human Genome Sequencing Center, where the sequencing will take place.
The contract is part of The Environmental Determinants of Diabetes in the Young project funded by the National Institute of Diabetes and Digestive and Kidney Diseases of the National Institutes of Health. The international project involves clinical centers at the University of Colorado in Denver; the Medical College of Georgia (involving Florida and Georgia); Pacific Northwest Diabetes Research Institute in Seattle, Washington; the University of Turku in Finland, the Diabetes Research Institute based in Munich, Germany; and Lund University in Malmo, Sweden. The data coordinating center is at the University of South Florida in Tampa. Dr. Jeffrey Krischer is director of the data coordinating center and the study co-chair of the TEDDY project.
National competition
"Baylor College of Medicine was chosen to do this very important analysis for TEDDY by way of a national competition that recognized the outstanding strengths of the faculty and technological resources of the Alkek Center for Metagenomics and Microbiome Research. TEDDY looks forward to the integration of the data to be produced at BCM with other genetics and exposure data as we attempt to unravel the causes of type 1 diabetes," said Krischer.
Over the past eight years, the project has enrolled more than 8,600 infants from populations of people predisposed to develop diabetes because of family history of the disease or other genetic determinants and those from the general population as well. Enrolled children will continue to be monitored until 15 years of age. Clinical samples are being collected from all the children and they and their families are asked to keep diaries of their diet, illnesses, allergies and other life experiences.
Clearer picture
"Over a million samples from the predisposed children and controls have already been collected," said Petrosino.
Researchers from institutions around the world are looking at many of the collected samples and other elements impacting the children’s lives, but the part of the study at BCM will look specifically at the microbiome in these youngsters. The research at the CMMR will include over 18,000 samples, and the microbiome analyses will be compiled with results from other facets of the TEDDY study to provide a clearer picture of progression to type 1 diabetes.
"We are looking for microbial associations with disease onset at the organism and genetic levels," said Petrosino. "Finding a potential viral trigger would be the Holy Grail of this kind of work, as it could lead to a preventive intervention. We also hope the data will help us to develop better diagnostic tools to monitor the progression to type 1 diabetics. Results from the systems biology approach TEDDY is following, that is, parallel studies in other ‘omics’—transcriptomics, metabolomics—fields as well as in the areas of immunology, toxicology, and epidemiology will hopefully reveal novel ways in which we can detect, treat, and perhaps prevent type 1 diabetes in the future."